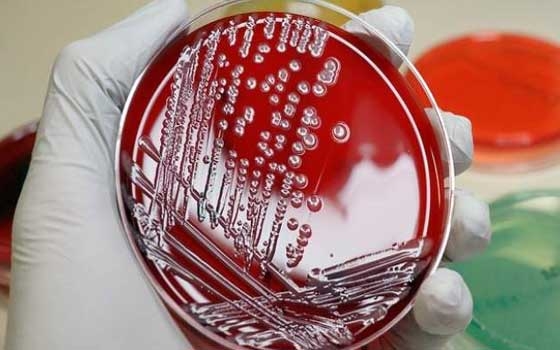
مصر اليوم - القومي للبحوث يتوصل لمشتقات البولي أميدات لمقاومة الميكروبات

الرئيسية
أخبارعاجلة
رياضة
- الأخبار الرياضية
- أخبار الرياضة
- فيديو أخبار الرياضة
- نجوم الملاعب
- اخبار الرياضة
- ملاعب مصرية
- بطولات
- أخبار الاندية المصرية
- مقابلات
- رياضة عربية
- رياضة عالمية
- موجب
- سالب
- مباريات ونتائج
- كرة الطائرة
- كرة اليد
- كرة السلة
- رمي
- قفز
- الجري
- تنس
- سيارات
- غولف
- سباق الخيل
- مصارعة
- جمباز
- أخبار المنتخبات
- تحقيقات
- مدونات
- أخبار المحترفين
ثقافة
إقتصاد
فن وموسيقى
أزياء
-
صحة وتغذية
-
سياحة وسفر
ديكور
القومي للبحوث يتوصل لمشتقات البولي أميدات لمقاومة الميكروبات
مضادات الميكروبات
القاهرة ـ مصر اليوم
أعد باحثون في شعبة الصناعات الكيماوية بالمركز القومي للبحوث مجموعة دراسات عن المركبات كبيرة الحلقة التي تحتوي على ذرات النيتروجين والكبريت والاكسجين (المكونة لأنوية البيريميدين و البيريدين والأحماض الأمينية (ودراسة تكوين مشتقاتها كأحد المحاور الهامة للحصول على مركبات جديدة لها فاعلية بيولوجية عالية كمضادات للبكتريا والطحالب والفطريات.
تعتبر مقاومة المضادات الحيوية ظاهرة خطيرة ومتنامية فى الطب المعاصر وبرزت كأحد مشكلات الصحة العامة البارزة فى القرن الواحد والعشرين وخاصة أنها تتعلق بعدد كبير من الميكروبات المسببة للأمراض، وتعود هذه الظاهرة إلى أمتلاك الميكروبات لمستوى عال من المقاومة الذاتية التى قد تتخذ شكل طفرة جينية عفوية أو متعمدة، وبذلك يمكن للميكروبات حاملة الجينات المقاومة للمضادات الحيوية أن تنتشر بسهولة وتصبح أكثر شيوعا مما يظهر زيادة الحاجة إلى البحث فى علاجات جديدة من المضادات الحيوية نظرا لإنخفاض المستمر فى عدد الأدوية المعتمدة حديثا.
وأثبتت أبحاث المركز أن التراكيب البنائية للمركبات الجديدة من خلال طرق التحاليل الدقيقة للعناصر، ودراسة أطياف الأشعة تحت الحمراء والرنين النووي المغناطيسي وطيف الكتلة. واختبرت الأبحاث الفاعلية البيولوجية للمركبات الجديدة المشيدة كمضادات للميكروبات المختلفة ممثلة بالبكتريا سالبة وموجبة الجرام وكذلك بعض الفطريات.
و أظهرت بعض المركبات فاعلية أعلى من المضاد الحيوى المستخدم كمرجع) الأمبيسيلين) ضد البكتريا موجبة وسالبة الجرام بينما أظهرت فاعلية أقل ضد الفطريات بالمقارنة مع عقار الكيتاكونازول.
GMT 08:12 2019 الأحد ,05 أيار / مايو
سكول فويس Schoolvoice ، حلول رائدة لتسهيل التواصل بين المدارس وأولياء الأمورGMT 13:36 2019 الجمعة ,03 أيار / مايو
أفكار إبداعية في تدريس مقررات الحاسب الآليGMT 12:34 2019 الخميس ,02 أيار / مايو
أدوات التحقق من الأخطاء النحوية في اللغة الإنجليزيةGMT 13:17 2019 الإثنين ,15 إبريل / نيسان
البحث العلمي والواقع التربويGMT 09:10 2019 الجمعة ,12 إبريل / نيسان
استخدام كاميرا 360 درجة في التعليمGMT 15:14 2019 الإثنين ,08 إبريل / نيسان
الفصول الدراسية في المستقبل من وجهة نظر التعليم الفنلنديGMT 16:19 2019 الأحد ,07 إبريل / نيسان
دراسة تؤكد أن تفاعل الآباء مع أطفالهم يجعلهم أكثر ذكاءGMT 12:08 2019 الجمعة ,05 إبريل / نيسان
التنمية المهنية للمعلم في العصر الرقميمن أجل إنهاء اعتماد الاقتصاد على النفط وتوفير فرص عمل
السعودية تضاعف أصول "صندوق الاستثمارات" إلى تريليون ريال
الرياض - مصر اليوم
أعلن ولي العهد السعودي الأمير محمد بن سلمان، أن الحكومة السعودية تقوم حالياً بالعمل على إنهاء اتفاقيات خصخصة تتجاوز قيمتها ملياري ريال (533 مليون دولار) قبل نهاية العام الجاري. وتمثل حملة الخصخصة جزءاً من "رؤية ال...المزيدكشفت أن حسن الرداد ليس دكتاتورًا
ناهد السباعي ترفض قطعيًا أن تكون الزّوحة الثّانية
القاهرة - مصر اليوم
حسمتْ الفّنانة المصرية ناهد السباعي، موقفها من الزّواج بعد أزمة انفصالها، أواخر العام الماضي، مؤكّدة، أنّها ليست مستعدّة للارتباط في الوقت الحاليّ نهائيًا. وشدّدت السباعي، خلال استضافتها في أحد البرامج التلفزيو...المزيدتُحدّد مكانه ومدى تشوه السطح في غضون أيام
صور الأقمار الصناعية تساهم في رصد الزلازل
واشنطن - مصر اليوم
أكد باحثون في جامعة أيوا والمسح الجيولوجي الأميركي، أن البيانات التي يتم جمعها من الأقمار الصناعية المدارية يمكن أن توفر معلومات أكثر دقة عن تأثير الزلازل الكبيرة، والتي يمكن أن تساعد في توفير استجابة أكثر فعالية ...المزيدنظمها «فريق فكر للقراءة» في الأحساء
نوف نبيل وبوخمسين يُبدعان في أمسية شعرية
المنامة - مصر اليوم
شاركت الشاعرة البحرينية نوف نبيل والشاعر سلمان بوخمسين في الأمسية الشعرية التي نظمها «فريق فكر للقراءة» التابع لجمعية الثقافة والفنون بالأحساء ضمن البرنامج الثقافي الخميس الماضي. وذكرت المشرفة على فريق فكر...المزيدضمن مباريات المجموعة الثالثة لـ"كوبا أميركا"
غيابات نجوم الإكوادور يُسهّل فوز أوروجواي
واشنطن- مصر اليوم
All rights reserved 2026 Arabs Today Ltd.
All rights reserved 2026 Arabs Today Ltd.

























































أرسل تعليقك